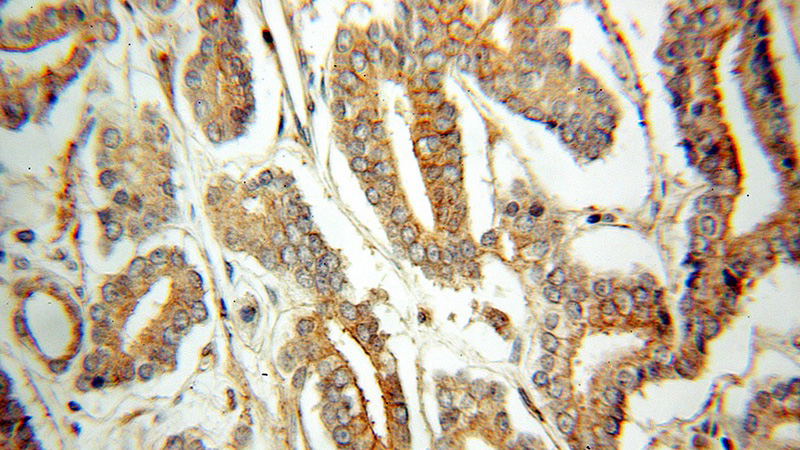
Immunohistochemical of paraffin-embedded human prostate cancer using Catalog No:110485(ETFDH antibody) at dilution of 1:50 (under 40x lens)

-
Product Name
ETFDH antibody
- Documents
-
Description
ETFDH Rabbit Polyclonal antibody. Positive IHC detected in human prostate cancer tissue, human kidney tissue, human liver tissue. Positive WB detected in mouse brain tissue, HEK-293 cells, human liver tissue, mouse kidney tissue, mouse liver tissue, mouse skeletal muscle tissue, rat brain tissue. Positive IP detected in mouse brain tissue. Observed molecular weight by Western-blot: 64kd
-
Tested applications
ELISA, IHC, IP, WB
-
Species reactivity
Human,Mouse,Rat; other species not tested.
-
Alternative names
ETF dehydrogenase antibody; ETF QO antibody; ETF ubiquinone oxidoreductase antibody; ETFDH antibody; ETFQO antibody; MADD antibody
-
Isotype
Rabbit IgG
-
Preparation
This antibody was obtained by immunization of ETFDH recombinant protein (Accession Number: NM_004453). Purification method: Antigen affinity purified.
-
Clonality
Polyclonal
-
Formulation
PBS with 0.1% sodium azide and 50% glycerol pH 7.3.
-
Storage instructions
Store at -20℃. DO NOT ALIQUOT
-
Applications
Recommended Dilution:
WB: 1:500-1:5000
IP: 1:200-1:2000
IHC: 1:20-1:200
-
Validations

IP Result of anti-ETFDH (IP:Catalog No:110485, 3ug; Detection:Catalog No:110485 1:500) with mouse brain tissue lysate 8000ug.
Immunohistochemical of paraffin-embedded human prostate cancer using Catalog No:110485(ETFDH antibody) at dilution of 1:50 (under 40x lens)

mouse brain tissue were subjected to SDS PAGE followed by western blot with Catalog No:110485(ETFDH Antibody) at dilution of 1:1000
-
Background
ETFDH(Electron transfer flavoprotein-ubiquinone oxidoreductase, mitochondrial) is also named as ETF-QO and belongs to the ETF-QO/fixC family.It is a 64-kDa monomer integrated in the inner mitochondrial membrane, con- tains one molecule of FAD and a 4Fe4S cluster(PMID:12815589).Defects in ETFDH are the cause of glutaric aciduria type 2C (GA2C).This antibody is speicific to ETFDH.
-
References
- Wen B, Dai T, Li W. Riboflavin-responsive lipid-storage myopathy caused by ETFDH gene mutations. Journal of neurology, neurosurgery, and psychiatry. 81(2):231-6. 2010.
- Wang ZQ, Chen XJ, Murong SX, Wang N, Wu ZY. Molecular analysis of 51 unrelated pedigrees with late-onset multiple acyl-CoA dehydrogenation deficiency (MADD) in southern China confirmed the most common ETFDH mutation and high carrier frequency of c.250G>A. Journal of molecular medicine (Berlin, Germany). 89(6):569-76. 2011.
Related Products / Services
Please note: All products are "FOR RESEARCH USE ONLY AND ARE NOT INTENDED FOR DIAGNOSTIC OR THERAPEUTIC USE"
